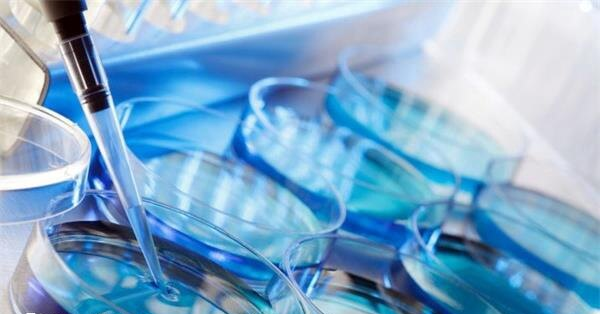
短方案通常从月经第2-3天启动促排

导读: 试管婴儿短方案通常从月经第2-3天启动促排,到取卵结束需8-12天,这包括打夜针后的时间。不过部分卵巢高反应患者,可能会将促排时间缩短至8天左右,而卵巢低反应者可能会延长促排时间至14天左右,具体还要根据个人情况进行综合判断,毕竟有的患者可能会使用降调,从而延长短方案促排时间。
试管婴儿短方案通常从月经第2-3天启动促排,到取卵结束需8-12天,这包括打夜针后的时间。不过部分卵巢高反应患者,可能会将促排时间缩短至8天左右,而卵巢低反应者可能会延长促排时间至14天左右,具体还要根据个人情况进行综合判断,毕竟有的患者可能会使用降调,从而延长短方案促排时间。
短方案促排时间及流程
短方案促排时,通常的取卵时间在促排后的10-15天进行取卵,举例如:如果直接进行促排的话,通常在8天的后进行夜针注射,并在第10天的时候进行取卵,这是最常规、最常见的时间(具体时间请参考医生的时间安排)。
1、降调阶段(可选)
部分患者需在月经第2天开始使用短效促性腺激素释放激素激动剂(如达必佳)进行降调,连续注射3天。
2、促排卵阶段
月经第3天开始使用促排卵药物(如果纳芬、丽申宝等),同时继续注射降调药物(若需要)。医生会根据卵泡发育情况和激素水平调整药物剂量。

3、卵泡监测
定期通过B超监测卵泡生长情况,并抽血检测雌激素等激素水平,以评估卵巢对药物的反应。
4、打夜针
当卵泡成熟时(通常在促排开始后的8-10天),注射人绒毛膜促性腺激素(HCG)或艾泽等药物,促使卵子最终成熟。
5、取卵
打夜针后36小时左右进行取卵手术。
需注意的是,关于短方案是否降调,其医生会根据患者体质决定患者是否需要降低这一个过程,如果不需要则不需要使用降调药物,如果需要降调则需要普瑞林以及达必佳药物进行降调。
上一篇:
湖南最好的不孕不育医院是哪家
下一篇:
选择日本还是美国冻卵
标签:
好孕交流群 分享心理 链接关系 共同目标
备孕优生
助您好孕多多
不孕不育
助您好孕多多




































